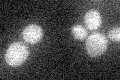
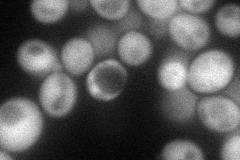

View description
Transcription factor that activates transcription of genes expressed at the M/G1 phase boundary and in G1 phase; localization to the nucleus occurs during G1 and appears to be regulated by phosphorylation by Cdc28p kinase
Localization:
Intensity:
Fold change:
Significance:
-
C’ GFP library in SD
below threshold15.61 -
N' NOP1pr-GFP in SD
cytosol77.6397 -
N' TEF2pr-mCherry in SD

cytosol94.6407 -
N' NATIVEpr-GFP in SD

nucleus38.4197 -
N' TEF2pr-VC and Cyto-VN in SD

below threshold24.3434 -
C’ GFP library in SD+DTT

cytosol16.961.08No -
C’ GFP library in SD+H2O2

cytosol16.861.07No -
C’ GFP library in Starvation Media

cytosol17.341.11No -
C’ GFP library on the background of Pup2-DaMP

below threshold -
C’ GFP library on the background of CCT mutant

below threshold16.42451.05177No
